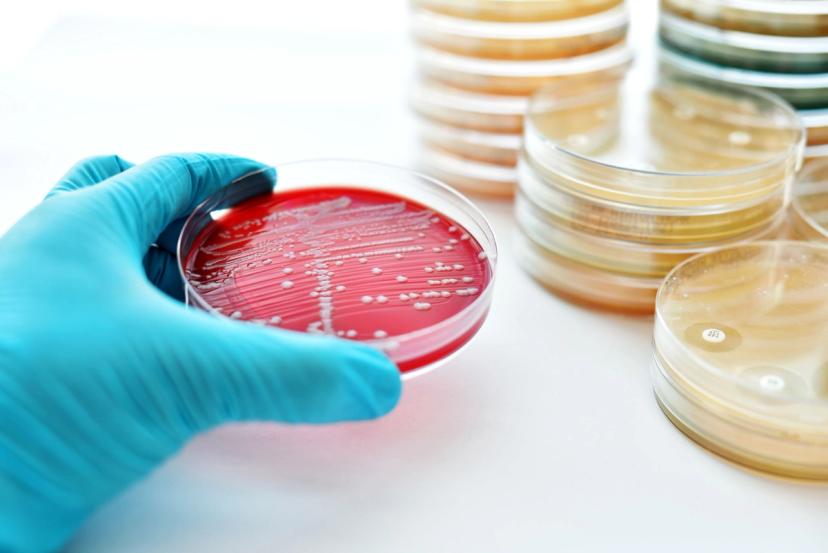
Clinical microbiologists play an essential role in preventing healthcare-associated infections by ensuring early detection

CLINICAL24: The role of clinical microbiologists in HAIs, AMR and beyond
25 Oct 2024
Clinical microbiologists play a crucial role in preventing healthcare-associated infections by ensuring early detection
Guest editorial by Ni Luh Putu Harta Wedari, Clinical Microbiologist for the Intisari Sains Medis Incorporation and an AMI Global Ambassador for Indonesia, published as part of the global CLINICAL24 conversation.
Healthcare-associated infections (HAIs) account for five to ten percent of hospital admissions globally, making them one of the most frequent adverse events occurring in the context of healthcare. In the U.S., HAIs are linked to a high rate of morbidity and mortality, accounting for about 90,000 fatalities annually.
Clinical microbiologists and healthcare-associated infections
Clinical microbiologists are essential to preventing healthcare-associated infections (HAIs) as early detection is the first step toward avoiding infections. Clinical microbiology contributes to several important aspects of infection prevention, such as (i) surveillance, (ii) managing and detecting outbreaks, (iii) antibiotic usage, (iv) infection control committee discussions, and (v) education and training. As clinical microbiologists contribute to the mission of HAI prevention, they encounter key challenges in each area.
The most crucial role of a clinical microbiologist in surveillance is to quickly and correctly identify HAIs and associated antibiotic resistance patterns. Data evaluation is still the most popular case-finding technique in HAI surveillance. Clinical microbiologists must also collaborate with the relevant information technology (IT) and infection prevention and control (IPC) programs to decide how microbiology data will be sent and connected to other surveillance data.
Clinical microbiologists face several surveillance challenges, such as the ongoing emergence of novel infectious agents (such as the H1N1 influenza A virus in 2009), the emergence of novel antimicrobial-resistant pathogens like Carbapenem-Resistant Enterobacteriaceae (CRE) and Methicillin-Resistant Staphylococcus aureus (MRSA), and the requirement for active surveillance and reporting of HAI case rates.
Clinical microbiologists should be able to yield data quickly, as during longer hospital stays, identification of bacteria is more difficult after eradication with antibiotics. A program for tracking and preventing infections in the hospital context should be implemented at every healthcare facility. Supported by laboratory technology such as the VITEK® 2 COMPACT system, such programs can help with identification and antimicrobial susceptibility.
Outbreak management and detection

Clinical microbiology is crucial in detecting and managing outbreaks
Clinical microbiology is crucial in detecting and managing outbreaks. This includes early identification of possible clusters and outbreaks, prompt notification and coordination with Infection Prevention and Control (IPC), further case finding, and molecular typing for linkages.
Clinical microbiologists must serve as a consultative entity with the IPC program to ascertain whether an epidemic is authentic or possibly a pseudo-outbreak stemming from specimens that have been contaminated, either inside or outside the laboratory. Finding outbreaks early enough to enable efficient interventions that reduce morbidity and death is a significant problem for clinical microbiologists since outbreaks are frequently discovered retroactively – either after they have been confined or started to fade.
In the future, real-time data and data-mining technologies that can identify shifts in positive test findings will probably provide early detection.
Antimicrobial stewardship
The inability to quickly and effectively get antibiotic susceptibility data from the clinical microbiology laboratory poses a significant obstacle to good stewardship.
Antimicrobial stewardship programs should be present in every hospital by now. The clinical laboratory’s results provide the foundation for antimicrobial stewardship initiatives, so good communication between the clinical pharmacology, IPC, and stewardship teams is crucial.

Antimicrobial stewardship programs are a health-care system wide approach to promoting and monitoring judicious use of antimicrobials
A personalized, unit-specific antibiogram should be updated often and shared with clinicians to direct empirical antibiotic therapy. Data from antibiograms can also be used to assess patterns in resistance levels and instruct medical professionals on the best ways to utilize antibiotics. Patient-specific culture and susceptibility data are necessary for directed antimicrobial therapy, as well as to enable an audit of antimicrobial use and provide prescribers with feedback.
The first step is to shorten the turnaround time for analytical results. The data must be promptly integrated, which is frequently not feasible if time-consuming record reviews are necessary for every patient. By identifying opportunities to optimize therapy through real-time analysis from several sources, including pharmacies, electronic medical records, and labs, computer support systems can deal with these problems.
Committees and expertise
The clinical microbiologist must participate in infection control committees and serve as a consultant to those involved in infection prevention initiatives. According to a comprehensive study of clinical microbiology laboratory leaders in both high-income and low- and middle-income countries, hospitals with clinical microbiology leaders were involved in formulary decisions, yearly antibiogram development, and molecular typing support.
Additionally, clinical microbiologists are essential to training hospital epidemiologists and infection prevention staff. Most epidemiologists have training in infectious diseases; others have experience as clinical microbiology laboratory directors and laboratory technicians.
Current trends and recommendations
Some current trends pose difficulties for clinical microbiologists and IPC interaction. Clinicians and infection prevention staff are frequently turned off from clinical microbiology laboratories due to the availability of only one dedicated facility for microbiology in a given area, and the preference for electronic medical records over in-person observations (such as plate review and Gram stain).
Another challenging aspect is the laboratory’s capacity to identify MDR-GNRs or distinguish those needing further infection control measures (such as contact precautions or transmission investigations) from those that do not.
Modifications to the Hodge test for confirmatory ESBL testing are no longer necessary due to changes in Clinical and Laboratory Standards Institute (CLSI) breakpoints for Enterobacteriaceae, cephalosporins, and carbapenems. The efficacy of therapies against distinct forms of MDR-GNR, and the efficiency of precautions to prevent MDR-GNR transmission remains a challenge.
Clinical microbiologists, as a crucial component of IPC, can assist healthcare administrators in understanding the need for proper funding of the laboratory. Although efficient infection control lowers expenses and saves lives, clinical microbiology laboratories seldom recognize this.
Every clinical microbiology laboratory should have a quality assurance process in place. Additionally, the laboratory should, if feasible, perform external quality control on essential operations. Significant advancements in molecular typing and precise diagnostic tools have contributed to the importance of clinical microbiology in recent decades.
In summary, a clinical microbiologist has two primary roles: first, they diagnose infections in individual patients; second, they prevent and control healthcare-associated infections. If the etiology of an illness can be quickly and accurately identified, severe HAIs can be prevented by ensuring that patients receive the proper care.
Published as part of the global CLINICAL24 conversation highlighting challenges facing clinical laboratories and exploring the technology solutions to overcome them. In partnership with Applied Microbiology International (AMI).